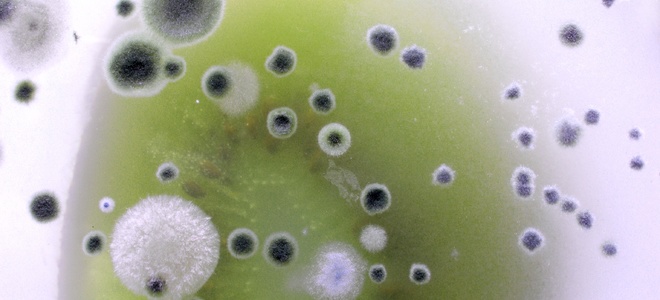
Eliminación de moho o hongos de los conductos

-

Hollow Knight: Guía de mapa de conductos de Silksong – Potrificado
Caballero Hollow: SilksongLos conductos putrificados son un área útil para visitar en el Acto 2, pero pueden ser un poco difíciles de encontrar y navegar. Es probable que pase por un conveniente punto de entrada a los conductos relativamente temprano en su exploración, pero hasta que obtenga la capa de Faydown y obtenga la capacidad…
-

Destiny 2: Cómo desactivar los conductos en The Temptation Quest (Psion Puzzle)
Destino 2: La forma final se parece a todos los demás Destino entrega en su amor por los rompecabezas, y Psion Puzzle aparece en La forma finalLa campaña en clásico. Destino moda, como el “De cabeza” rompecabezas de la caída de luz Contenido descargable. Durante el “Tentación” línea de misiones que ocurre al principio de…
-

Cómo limpiar el moho de los conductos
Conocimiento como limpiar el moho es una habilidad vital si ha encontrado un espacio para crecer en su edificio. La humedad puede acumularse en los conductos de ventilación debido a la condensación o las fugas. Esto abre un punto de apoyo para las esporas de moho. Para purgar el moho, tendrá que desalojar el edificio…
-

Cómo limpiar sus conductos de aire
Hay varias razones y formas diferentes de limpiar su conductos de aire. Si usted o alguien de su familia tiene alergias, limpiar sus conductos de aire puede mejorar significativamente su salud. A continuación, encontrará algunos consejos sobre cómo mantener los conductos de aire libres de polvo y moho. Paso 1 – Cuándo limpiar Es importante…
-

Cómo deshacerse de los murciélagos del ático en los conductos de ventilación
Los murciélagos del ático son simplemente una molestia. Una vez que tenga algunas, pueden convertirse rápidamente en una colonia y deberán tratarse. Pero si bien son plagas, los murciélagos también son animales que necesitan protección. La solución no es dañar o matar a los murciélagos, sino mantenerlos alejados de su ático. Válvula de una vía…
-

Cómo eliminar el olor a humo de cigarrillo de los conductos de aire
El olor a humo de cigarrillo puede resultar bastante irritante para los no fumadores. Por lo tanto, eliminar el olor a humo de los conductos de aire se convierte en un trabajo de bricolaje esencial que, aunque moderadamente fácil, aún requiere orientación para garantizar que el objetivo se haya logrado por completo. Paso 1: Identifique…
-
Eliminación de moho o hongos de los conductos
Si tiene conductos que actualmente están plagados de moho o hongos, es posible que se pregunte cómo eliminarlos. Si es así, siga leyendo para aprender todo lo que necesita saber sobre cómo purgar eficazmente el moho de sus conductos. Paso 1 – Protéjase Antes de proceder a purgar el moho que ha infestado sus conductos,…